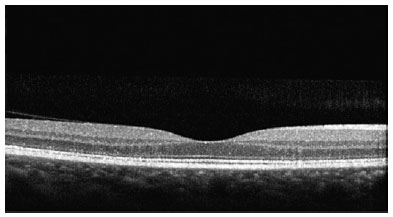
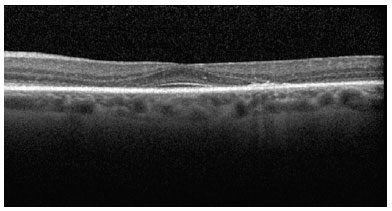

Renata Tavares de Souza Cabral1; Evandro Mendes Klumb2; Maria Isabel Noronha Neta Couto3; Sueli Carneiro4
DOI: 10.5935/0004-2749.20190002
ABSTRACT
Purpose: To investigate the frequency of toxic retinopathy in patients with lupus erythematosus and rheumatoid arthritis with long-term use of chloroquine diphosphate or hydroxychloroquine through spectral domain optical coherence tomography and the outcomes of ophthalmological exams (visual acuity - Snellen’s table, color vision test - Ishihara’s table, fundoscopy, and retinography - red-free).
Methods: A cross-sectional study was carried out involving the ophthalmologic evaluation of patients using regular chloroquine diphosphate or hydroxychloroquine for a period of 1 year or longer. The patients completed a questionnaire on their opinions and treatment regularity. The same patients underwent ophthalmologic examination and spectral domain optical coherence tomography.
Results: The prevalence of toxic retinopathy caused by antimalarials was 4.15% (9 of 217 patients), 7.4% (4 of 54 patients) following chloroquine diphosphate usage, and 0.82% (1 of 121 patients) following hydroxychloroquine usage. Only patients with advanced stage maculopathy presented abnormalities during the ophthalmologic exam: the color vision test was altered in 11.1%, and visual acuity and fundoscopy were altered in 33.3%. Identification of early toxic retinopathy, detected in six patients, was possible using spectral domain optical coherence tomography. The mean duration of antimalarial drug usage among patients with toxic retinopathy was 10.4 years. Only 31% of the patients reported some symptoms during treatment, and although 24% were afraid to use the medication, they did so as prescribed.
Conclusion: Use of spectral domain optical coherence tomography was essential for the diagnosis of early-stage antimalarial toxic retinopathy in patients with the following characteristics: asymptomatic, antimalarial use 7 days a week for a period of more than 5 years, and normal clinical ophthalmologic examination.
Keywords: Retinopathy/etiology; Antimalarials/adverse effects; Hydroxychloroquine/adverse effects; Chloroquine/adverse effects; Tomography, optical coherence/methods
RESUMO
Objetivo: Investigar a frequência da retinopatia tóxica em pacientes com lúpus eritematoso e artrite reumatóide com uso crônico de difosfato de cloroquina ou hidroxicloroquina, através de tomografia de coerência óptica de domínio espectral e os resultados dos exames oftalmológicos (acuidade visual - tabela de Snellen, teste de visão de cor - tabela de Ishihara, fundoscopia e retinografia - red free).
Métodos: Foi realizado um estudo transversal envolvendo a avaliação oftalmológica de pacientes em uso regular de difosfato de cloroquina ou hidroxicloroquina por um período de um ano ou mais. Os pacientes responderam a um questionário sobre a sua opinião e regularidade do tratamento. Os mesmos pacientes realizaram exame oftalmológico clínico e tomografia de coerência óptica de domínio espectral.
Resultados: A prevalência de retinopatia tóxica por antimaláricos foi de 4,15% (9 dos 217 pacientes), 7,4% (4 de 54 pacientes) após uso de difosfato de cloroquina e 0,82% (1 de 121 pacientes) após uso de hidroxicloroquina. Apenas os pacientes com maculopatia em fase avançada apresentaram alterações durante os exames clínicos: teste de visão de cores alterado em 11,1%, e a acuidade visual e fundoscopia foram alteradas em 33,3%. A identificação de retinopatia tóxica precoce, detectada em seis pacientes, foi possível por meio da tomografia de coerência óptica de domínio espectral. A duração média do tempo de uso de drogas antimaláricas entre os pacientes com retinopatia tóxica foi de 10,4 anos. Apenas 31% dos pacientes relataram algum sintoma durante o tratamento e apesar de 24% terem medo de usar a medicação, eles o fizeram conforme prescrito.
Conclusão: O uso da tomografia de coerência óptica de domínio espectral foi essencial para o diagnóstico de retinopatia tóxica antimalárica em estágio inicial em pacientes com as seguintes características: uso assintomático, antimalárico 7 dias por semana por um período maior que cinco anos e exame oftalmológico clínico normal.
Descritores: Retinopatia/etiologia; Antimaláricos/efeitos adversos; Hidroxicloroquina/efeitos adversos; Cloroquina/efeitos adversos; Tomografia de coerência óptica
INTRODUCTION
Toxic retinopathy (TR) caused by antimalarials, first described in 1951, is a rare adverse effect that causes irreversible vision loss(1-4). Currently, additional ophthalmologic tests enable the early diagnosis of maculopathy, even in asymptomatic patients(4-10). The prevalence of TR differs among antimalarials. For chloroquine diphosphate (CQ), a frequency ranging from 2.5% to 10% has been reported(11-13).
The risk factors for antimalarial TR described by the American Academy of Ophthalmology in 2016 were categorized as major and minor. The minor risk factors are age over 60 years, presence of liver disease, and generic factors (anomaly in ABCA423-2016 or P45024-2016 gene 4). On the other hand, the major risk factors are period of exposure greater than 5 years, nephropathy, concomitant use of tamoxifen, previous presence of maculopathy, and dose/kg of antimalarials (for hydroxychloroquine - HCQ, greater than 5.0 mg/kg of actual weight and for CQ, greater than 2.3 mg/kg of actual weight)(4).
Some articles consider cumulative dose as the most important risk factor. A daily dose of CQ greater than 250 mg/day or greater than 4 mg/kg/day and of HCQ greater than 400 mg/day or greater than 6.5 mg/kg/day translates to an accumulated risk greater than 460 g for CQ and greater than 1000 g for HCQ(2,3,5,8,14-19).
In the pre-macula stage, spectral domain optical coherence tomography (SD-OCT) can detect alterations in the photoreceptor layer, at the junction of the internal and external segments of the retina (ISOS), and in the retinal pigment epithelium (RPE). It is possible to identify discrete irregularities in the bilateral perifoveal region. In the initial phase of TR, small faults can be detected in the photoreceptor layers, ISOS, and RPE in the perifoveal region in addition to the above irregularities.
At the moderate maculopathy stage, loss of the physiological depression of the fovea occurs with interruptions of the RPE and ISOS in the parafoveal and perifoveal macular regions, characterizing the aspect in comet and macula in target. In the moderate and advanced stages, a typical fundoscopic TR lesion in the form of a bull’s eye can be identified, resulting from antimalarials. The advanced stage of maculopathy occurs with increased atrophy, foveal disruption, and visual acuity loss(15).
There is still no gold standard test for the diagnosis of toxic maculopathy, which makes it difficult to assess the sensitivity and specificity of diagnostic methods. The additional ophthalmologic tests described for the diagnosis of toxic maculopathy are multifocal electroretinography (mfERG), which has a sensitivity of 92.9% and specificity of 86.9%; computerized visual field, which has a sensitivity of 92.5% and specificity of 85.7%; and SD-OCT, which has a sensitivity of 78.6% and specificity of 98.1%(5,14).
This article describes the frequency of TR assessed using SD-OCT in patients with lupus erythematosus (LE) and rheumatoid arthritis (RA) with long-term use of chloroquine diphosphate (CQ) or hydroxychloroquine (HCQ) and the outcome of clinical ophthalmological exams (visual acuity tests - Snellen’s table, color vision test - Ishihara’s table, fundoscopy, and retinography - red-free).
METHODS
A cross-sectional study of outpatients at the Ophthalmology Service from November 2012 to October 2014, who were regular users of CQ and/or HCQ for a period longer than 1 year, was conducted. The study protocol was approved by the Research Ethics Committee, and the patients signed a free and informed consent form.
Three hundred patients answered a questionnaire about the frequency, regularity, and duration of medication use, the presence of adverse events, their level of knowledge about the drugs used, and their degree of satisfaction with the treatment. Patients with ocular disease such as optic neuropathy, glaucoma, vascular occlusion, or degenerative maculopathy were excluded. After exclusion, 217 patients were eligible for the study.
The ophthalmologic examination included a visual acuity test with the Snellen Table, refraction, a color vision test (Ishihara Table), biomicroscopy, applanation tonometry, and fundoscopy with mydriasis. Subsequently, the Heidelberg Spectralis SD-OCT test (from Heidelberg Engineering, Heidelberg, Germany) was performed(3-6,14,15).
RESULTS
Of the 217 patients, 208 (95.85%) had normal ophthalmological and SD-OCT results. The prevalence of TR caused by antimalarials was 4.15% (95% CI: 0.015 to 0.068), occurring in 9 of 217 patients. These nine patients were all women between 41 and 60 years of age, who regularly used one antimalarial tablet per day (5-7 days a week according to the medical prescription). The prevalence of toxic maculopathy was 7.4% from CQ usage (4 of 54 patients; 95% CI: 0.0042 to 0.143) and 0.82% from HCQ usage (1 in 121 patients; 95% CI: 0.00786 to 0.02438). The prevalence when CQ was later replaced with HCQ was 9.52% (95% CI: 0.0064 to 0.1836), occurring in 4 of 42 patients.
The prevalence of TR was higher in the 41-to-50-year-old age group (55.6%). TR developed in 6 of 153 patients (66.7%) with a diagnosis of LE and in 3 of 64 patients (33.3%) with RA. Among the nine patients with TR, one patient used HCQ, and eight used CQ (four of them only at the beginning of the treatment, after which they switched to HCQ). The prevalence of TR was similar in both diseases. Most of the patients had used CQ at some point.
The duration of antimalarial medication use by patients with TR varied from 5 to 14 years, with a mean duration of 10.4 years and a standard deviation of 2.45 (Table 1).

Of the 19 patients who did not take antimalarial medication at the time of the research but had previously taken it regularly, 36.8% (7) claimed that the medication was stopped by their physicians because of complications, 31.6% (6) reported that they switched to a different medication without stating the reason, and 31.6% (6) suspended their own medication out of fear of taking the drug. However, most patients with TR (66.7%, 6) stated that they were not afraid to use the medication and that they were satisfied with it. Only one patient with HCQ use of more than 10 years developed TR, diagnosed at a moderate stage.
Only 31% of antimalarial users reported some symptoms during treatment, such as altered skin color (40), blurred vision (31), headache (24), and tinnitus (22). Three (33.3%) TR patients had symptoms (altered skin color in two patients, dizziness, red eyes, headache, tinnitus, and blurred vision), and the other six (66.7%) remained asymptomatic throughout treatment.
The results were normal for 66.7% (6) of the patients with TR in the visual acuity test, for 88.9% (8) in the color vision test, and for 66.7% (6) in fundoscopy (Table 2). Most patients with TR (55.6%) had an ophthalmologic exam annually but did not undergo additional exams. One patient who had been using the drug for 5 years had the test performed just before starting treatment, and one third of patients had periodic clinical exams but not SD-OCT. Therefore, they were not diagnosed with maculopathy and continued to use antimalarials.

SD-OCT was useful for the classification of TR. Of the nine patients with TR caused by antimalarials, 44% (4) presented premacular maculopathy (Figure 1), 22% (2) at the initial stage (Figure 2), 22% (2) at the moderate stage (Figure 3), 11% (1) at the advanced stage (Figure 4), and none at the terminal stage (Table 3).

This exam enabled a diagnosis of early-stage TR in six patients who were still asymptomatic and had normal routine eye examinations.
DISCUSSION
When CQ and HCQ users were analyzed separately, the prevalence of TR caused by CQ (7.4%) was lower than that reported by Bernstein (10%) and higher than that demonstrated by the meta-analysis conducted by Ruiz Irastorza (ophthalmology examination and OCT). Bicas Neto & Mesquita observed TR by OCT in two patients using CQ for almost 5 years(9,12).
Regarding HCQ, the value found (0.82%) was lower than that described by Bernstein (3%-4%) and much lower than that described by Merlles & Marmor (7.5%). However, it was higher than that reported by Ruiz Irastorza et al. (0.1%). Both drugs are recommended for the treatment of RA and LE. However, HCQ is described as having less toxicity, and therefore, it is more often prescribed(9,11,13,16,17).
The main reason for discontinuation of treatment, reported by a little more than a third of the patients, was ophthalmological complications. However, the majority had been misdiagnosed with TR using normal SD-OCT and could return to treatment. On the other hand, a third of patients with TR expressed fear of using the medication, but continued to use it anyway according to the prescription(9-12,20,21).
More than half of patients with TR used the medication 7 days a week, taking 1 tablet per day according to the medical prescription without reaching the maximum dose. Durcan et al., in 2015, reported that the blood level of the prescribed medication may not correspond to the quantity administered to the patient because of non-adherence to treatment. Adherence to treatment in LE and RA ranges from 31.7% to 45.9%(6,21,22-24).
The TR prevention protocol recommends a prior ophthalmic examination before the start of treatment or in the first year of exposure. This is the baseline ophthalmic examination. The second examination should include additional ophthalmologic tests, and SD-OCT may be considered. In patients taking the medication for less than 5 years with an adequate dosage for weight, monitoring can be done after 5 years of exposure(4).
After 5 years of continuous use of antimalarials, the risk of TR increases to 1%(2). After 20 years of use, the risk increases to 20%. Most patients tested, 63.15%, had used the medication for a period of 5 years or more and 27.65%, for a period of 10 years or more. Almost 80% of TR patients used the medication for a period of 10 years or more, placing them at risk because of cumulative dose and exposure time(4,10,13).
The clinical ophthalmologic examination was normal for most patients, regardless of their complaints. One complained of blurred vision and three others, low vision. The occurrence of a reduction in vision depends on professional activity, and the progressive loss of light vision depends on damage to the macular area. Patients are the most likely to notice moderate vision loss; however, by this stage, severe TR with permanent visual damage already exists. Initial maculopathy occurs outside the center of the fovea and progressively expands its involvement throughout the macular region. Therefore, even with maculopathy, it is possible for the patient to have normal vision at the beginning(2,5,14,17,25).
Only one patient with severe maculopathy presented alterations in the color vision test. The other six did not complain during the anamnesis and had normal ophthalmologic examinations and retinography (infrared). The only altered examination was the optical cut of the SD-OCT, which showed four patients with premacular maculopathy and two with initial maculopathy.
Related symptoms may occur during treatment at different stages but do not appear frequently. Dry eye was a frequent complaint, but is not described as an adverse effect of the medication, being related to connective tissue disorders, in addition to being common among middle-aged women because of hormonal variation. Blurred vision was resolved after refractive examination with the prescription of corrective lenses. It was not related to maculopathy, but to presbyopia(1,10,16-21,26-30).
In a study carried out in São Paulo, Brazil, adverse effects were reported by 35.7% of patients: 17% reported ocular alterations; 10%, gastrointestinal; 3.4%, dermatological; 1.7%, neuromuscular; and 0.3%, psychiatric, leading 22.9% of them to discontinue treatment. In another study, gastrointestinal and ocular manifestations were the most common complaints. However, both articles emphasized that antimalarials are well accepted by users(10,17,26).
The prevalence of TR in association with antimalarials detected using SD-OCT was 4.15%. The specific prevalence for CQ was 7.4% and that for HCQ, 0.82%. The values found are in accordance with the literature. The ophthalmologic examination in users of antimalarials for both symptomatic and asymptomatic patients was normal in most cases. SD-OCT was essential for the diagnosis of TR in the early stage, observed in six patients with the following characteristics: asymptomatic, using medication 7 days a week for a period of more than 5 years, along with normal ophthalmologic examination. In addition, patients felt safe and comfortable with the use of antimalarials, and only a third of patients reported some symptoms during treatment.
REFERENCES
1. Bernatsky S, Pineau C, Joseph L, Clarke A. Adherence to ophthalmologic monitoring for antimalarial toxicity in a lupus cohort. J Rheumatol. 2003;30(8):1756-60.
2. Marmor MF, Kellner U, Lai TY, Lyons JS, Mieler WF; American Academy of Ophthalmology. Revised recommendations on screening for chloroquine and hydroxychloroquine retinopathy. Ophthalmology. 2011;118(2):415-22.
3. Michaelides M, Stover NB, Francis PJ, Weleber RG. Retinal toxicity associated with hydroxychloroquine and chloroquine: risk factors, screening, and progression despite cessation of therapy. Arch Ophthalmol. 2011;129(1):30-9.
4. Marmor MF, Kellner U, Lai TY, Melles RB, Mieler WF; American Academy of Ophthalmology. Recommendations on Screening for Chloroquine and Hydroxychloroquine Retinopathy (2016 Revision). Ophthalmology. 2016;123(6):1386-94.
5. Missner S, Kellner U. Comparison of different screening methods for chloroquine/hydroxychloroquine retinopathy: multifocal electroretinography, color vision, perimetry, ophthalmoscopy, and fluorescein angiography. Graefes Arch Clin Exp Ophthalmol. 2012; 250(3):319-25.
6. Stepien KE, Han DP, Schell J, Godara P, Rha J, Carroll J. Spectral-domain optical coherence tomography and adaptive optics may detect hydroxychloroquine retinal toxicity before symptomatic vision loss. Trans Am Ophthalmol Soc. 2009;107:28-33.
7. Kiernan DF, Mieler WF, Hariprasad SM. Spectral-domain optical coherence tomography: a comparison of modern high-resolution retinal imaging systems. Am J Ophthalmol. 2010;149(1):18-31.
8. Weinlander E, Ringeisen AL, Mititelu M. Retinopathy in the Era of Routine Hydroxychloroquine Monitoring. J Rheumatol. 2016; 43(6):1254.
9. Biccas Neto L, Mesquita AS. [Toxic maculopathy caused by antimalarial drugs: detection using spectral domain OCT: case reports]. Arq Bras Oftalmol. 2009;72(5):710-4. Portuguese.
10. Costedoat-Chalumeau N, Dunogué B, Leroux G, Morel N, Jallouli M, Le Guern V, et al. A critical review of the effects of hydroxychloroquine and chloroquine on the eye. Clin Rev Allergy Immunol. 2015;49(3):317-26.
11. Ruiz-Irastorza G, Ramos-Casals M, Brito-Zeron P, Khamashta MA. Clinical efficacy and side effects of antimalarials in systemic lupus erythematosus: a systematic review. Ann Rheum Dis. 2010; 69(1):20-8.
12. Bernstein HN. Ophthalmologic considerations and testing in patients receiving long-term antimalarial therapy. Am J Med. 1983;75(1 1A): 25-34.
13. Melles RB, Marmor MF. The risk of toxic retinopathy in patients on long-term hydroxychloroquine therapy. JAMA Ophthalmol. 2014; 132(12):1453-60.
14. Chen E, Brown DM, Benz MS, Fish RH, Wong TP, Kim RY, et al. Spectral domain optical coherence tomography as an effective screening test for hydroxychloroquine retinopathy (the “flying saucer” sign). Clin Ophthalmol. 2010;4:1151-8.
15. Wu L, Alpizar-Alvarez N. Choroidal imaging by spectral domain-optical coherence tomography. Taiwan J Ophthalmol. 2013;3(1):3-13.
16. Laçava AC. Complicações oculares da terapêutica com a cloroquina e derivados. Arq Bras Oftalmol. 2010;73(4):384-9.
17. Ponchet MR, Vilela MA, Sinahara KK, Dotto PF. Avaliação dos efeitos adversos desencadeados pelo uso de difosfato de cloroquina, com ênfase na retinotoxicidade, em 350 doentes com lúpus eritematoso. An Bras Dermatol. 2005;80 Suppl 3:S275-82.
18. Wolfe F, Marmor MF. Rates and predictors of hydroxychloroquine retinal toxicity in patients with rheumatoid arthritis and systemic lupus erythematosus. Arthritis Care Res (Hoboken). 2010;62(6): 775-84.
19. Pasadhika S, Fishman GA. Effects of chronic exposure to hydroxychloroquine or chloroquine on inner retinal structures. Eye (Lond). 2010;24(2):340-6.
20. Nebbioso M, Livani ML, Steigerwalt RD, Panetta V, Rispoli E. Retina in rheumatic diseases: standard full field and multifocal electroretinography in hydroxychloroquine retinal dysfunction. Clin Exp Optom. 2011;94(3):276-83.
21. Kanski JJ. Doenças sistêmicas. In: Oftalmologia clínica: uma abordagem sistemática. 6a ed. Rio de Janeiro: Elsevier; 2008. p. 869-921.
22. Durcan L, Clarke WA, Magder LS, Petri M. Hydroxychloroquine Blood Levels in Systemic Lupus Erythematosus: Clarifying Dosing Controversies and Improving Adherence. J Rheumatol. 2015;42(11):2092-7.
23. Oliveira-Santos M, Verani JF, Camacho LA, de Andrade CA, Ferrante- Silva R, Klumb EM. Effectiveness of pharmaceutical care for drug treatment adherence in patients with systemic lupus erythematosus in Rio de Janeiro, Brazil: study protocol for a randomized controlled trial. Trials. 2016;17(1):181.
24. Prudente LR, Diniz JS, Ferreira TX, Lima DM, Silva NA, Saraiva G, et al. Medication adherence in patients in treatment for rheumatoid arthritis and systemic lupus erythematosus in a university hospital in Brazil. Patient Prefer Adherence. 2016;10(10):863-70.
25. Kanski JJ. Técnica de Exame ocular. In: Oftalmologia clínica: uma abordagem sistemática. 6a ed. Rio de Janeiro: Elsevier; 2008. p.1-24.
26. Costedoat-Chalumeau N, Dunogué B, Morel N, Le Guern V, Guettrot-Imbert G. Hydroxychloroquine: a multifaceted treatment in lupus. Presse Med. 201443(6 Pt 2):e167-80.
27. Gass JD. Toxic disease affecting the pigment epithelium and retina: chloroquine (Aralen®) and hydroxicloroquine (Plaquenil®) retinopathy. In: Gass JD, editor. Stereoscopic atlas of macular diseases: diagnosis and treatment. 4th ed. St. Louis: Mosby; 1997. pp. 457-73.
28. Kanski JJ. Distúrbios Induzidos por medicamentos. In: Oftalmologia clínica: uma abordagem sistemática. 6a ed. Rio de Janeiro: Elsevier; 2008. p. 841-4.
29. Fonseca EC, Arruda GV, Rocha EM. Olho seco: etiopatogenia e tratamento. Arq Bras Oftalmol. 2010;73(2):197-203.
30. Werner L, Trindade F, Pereira F, Werner L. Fisiologia da acomodação e presbiopia. Arq Bras Oftalmol. 2000;63(6):487-93.
Submitted for publication:
January 10, 2018.
Accepted for publication:
May 27, 2018.
Approved by the following research ethics committee: Hospital Universitário Pedro Ernesto (CAAE: 06114912.2.0000.5259)
Funding: No specific financial support was available for this study
Disclosure of potential conflicts of interest: None of the authors have any potential conflicts of interest to disclose